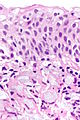

Signet ring cell carcinoma
Jump to navigation
Jump to search
| Signet ring cell carcinoma | |
|---|---|
| Diagnosis in short | |
 Signet ring cell carcinoma. H&E stain | |
|
| |
| LM | ovoid cells with abundant cytoplasm and a peripheral crescentic hyperchromatic nucleus |
| LM DDx | serous fat atrophy, benign histiocytes (mucocele, xanthoma) |
| Stains | PAS stain |
| IHC | pankeratin +ve, CD68 -ve |
| Site | stomach, small intestine, large intestine, breast, pancreas, urinary bladder, prostate gland, lung |
|
| |
| Associated Dx | Invasive lobular carcinoma, mucinous carcinoma |
| Syndromes | familial diffuse gastric cancer |
|
| |
| Prevalence | uncommon |
| Endoscopy | linitis plastica (classic finding in the stomach) |
| Prognosis | poor |
| Signet ring cell carcinoma | |
|---|---|
| External resources | |
| EHVSC | 9982 |
| Wikipedia | Signet ring cell carcinoma |
Signet ring cell carcinoma, abbreviated SRCC, is a type of malignant epithelial neoplasm that can arise from a number of places. It is commonly associated with the stomach.
General
- Signet ring cell carcinoma are notoriously easy to miss in a small biopsy.
- It has been said that there are two types of pathologists... those that have missed SRCCs and those that will miss SRCCs.
- The name comes from the shape of cells. They look like signet rings that are lying flat on the ground and one is looking from above - see microscopic section.
Anatomical Site
It may arise from the:[1]
- Esophagus.
- >50% signet ring cells - as per a study definition.[2]
- Stomach.
- Small intestine
- Large intestine.
- Breast
- Pancreas.
- Urinary bladder.
- Prostate gland.
- Lung.
Microscopic
Features:
- Signet ring cells resemble signet rings.
- They contain a large amount of mucin, which pushes the nucleus to the cell periphery.
- The pool of mucin in a signet ring cell mimics the appearance of the finger hole.
- The nucleus mimics the appearance of the face of the ring in profile.
- Signet ring cells are typically 2-3x the size of a lymphocyte.
- Smaller than the typical adipocyte.
- Often have a crescent-shaped or ovoid nucleus.
- Capillaries sectioned on their lumen have endothelial cells - the nuclei of these are more spindled.
Note:
- SRCs are usually close to friend, i.e. they are adjacent to another SRC.
- This helps differentiate SRCs from capillaries sectioned on their lumen.
- The mucin is often clear on H&E... but maybe eosinophilic.
DDx:
- Serous fat atrophy.[3]
- Mucocele - muciphages may mimic signet ring cells.[4]
- Muciphages = cytoplasm lightly eosinophilic, multivaculated (classic) or finely reticulated.
- Gastric xanthoma.
- Goblet cell adenocarcinoma (crypt cell carcinoma or goblet cell carcinoid).[5]
- Ischemic mucosal changes - cells within the lumen.[6]
Images
www
Case - stomach
Case - bladder
Additional cases
Stains
- Alcian blue-PAS stain +ve (stomach and colorectum).[7]
- PAS stain +ve.
- Mucicarmine stain -ve (stomach).[citation needed]
Note:
- Mucin staining varies somewhat by the anatomical site.[8]
IHC
- AE1/AE3 +ve.
- CK7 +ve (usually).
See also
References
- ↑ URL: http://cancerhelp.cancerresearchuk.org/about-cancer/cancer-questions/what-is-a-signet-cell-cancer. Accessed on: 7 March 2012.
- ↑ URL: https://clinicaltrials.gov/ct2/show/NCT01824966. Accessed on: April 23, 2022.
- ↑ Clarke, BE.; Brown, DJ.; Xipell, JM. (Jan 1983). "Gelatinous transformation of the bone marrow.". Pathology 15 (1): 85-8. PMID 6222282.
- ↑ De Petris, G.; Lev, R.; Siew, S. (May 1998). "Peritumoral and nodal muciphages.". Am J Surg Pathol 22 (5): 545-9. PMID 9591723.
- ↑ Pericleous, M.; Lumgair, H.; Baneke, A.; Morgan-Rowe, L.; E Caplin, M.; Luong, TV.; Thirlwell, C.; Gillmore, R. et al. (May 2012). "Appendiceal goblet cell carcinoid tumour: a case of unexpected lung metastasis.". Case Rep Oncol 5 (2): 332-8. doi:000339607. PMID 22933998.
- ↑ Dhingra, S.; Wang, H. (Dec 2011). "Nonneoplastic signet-ring cell change in gastrointestinal and biliary tracts: a pitfall for overdiagnosis.". Ann Diagn Pathol 15 (6): 490-6. doi:10.1016/j.anndiagpath.2011.07.006. PMID 22082777.
- ↑ Terada, T. (2013). "An immunohistochemical study of primary signet-ring cell carcinoma of the stomach and colorectum: I. Cytokeratin profile in 42 cases.". Int J Clin Exp Pathol 6 (4): 703-10. PMID 23573317.
- ↑ Nguyen MD, Plasil B, Wen P, Frankel WL (June 2006). "Mucin profiles in signet-ring cell carcinoma". Arch Pathol Lab Med 130 (6): 799–804. doi:10.5858/2006-130-799-MPISCC. PMID 16740030.